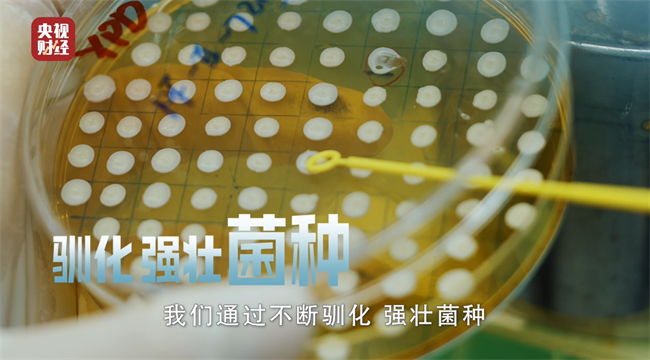

导语
“十五五”规划将生物制造列为未来六大产业之一,在这一国家战略背景下,总台主持人陈伟鸿走进巨子生物,深入了解并见证了“中国成分”重组胶原蛋白的科学原理、透皮吸收能力,以及从实验室克级到产业化吨级的效能跃升。从首个重组胶原中国发明专利、国家技术发明奖到透皮技术再突破,巨子生物以无可争议的科研实力和商业量产能力,让重组胶原蛋白走进亿万消费者的日常生活。
你有没有过这样的困惑——
每到换季,脸就“闹情绪”,干燥、泛红、敏感;明明面膜敷了、精华涂了,皮肤状态却依旧“掉线”;吃猪蹄、喝银耳汤,折腾半天,胶原蛋白还是没补进去?
这不是你一个人的烦恼。
胶原蛋白,是人体含量最丰富的蛋白质,约占人体蛋白质总量的30%,如同身体的“隐形钢筋网”,支撑着皮肤、骨骼、软骨和血管。然而,从25岁起,人体自身合成胶原的能力逐年下降,熬夜、压力、环境刺激等外在因素更让流失加速。皮肤松弛、细纹加深、屏障脆弱——这些信号,根源都在胶原蛋白的“库存告急”。
补胶原,几乎成了现代人的刚需。但如何让胶原蛋白真正“补进去”?怎么补,才有效?近日,总台主持人陈伟鸿带着这个“全民疑问”,走进了拥有20余年重组胶原蛋白技术积累和产业实践的巨子生物,试图从源头找寻“科学补胶原”的底层逻辑。在这里,我们看到了不同于以往的答案。

一、复刻:那颗改变一切的“种子”从何而来?
“重组胶原蛋白”,听起来像实验室里的生僻词。但在巨子生物首席技术官段志广的回答里,它被描述得相当“通俗且可爱”:
“所谓重组,就是通过合成生物学技术,把人体胶原蛋白的氨基酸序列精准‘复刻’出来。”段博士拿起一支试管,里面装着乳白色的菌种,“这些微生物就是我们生产胶原蛋白的‘种子’。它们被导入人胶原蛋白的基因,在严格控制的发酵环境中,源源不断地产出和人体同源的重组胶原蛋白。”

跟传统方式提取的胶原蛋白不同,重组技术的核心优势在于“同源”与“可控”。同源,意味着生物活性更高、免疫排异风险更低;可控,意味着序列、纯度、稳定性都能达到医用级标准,品质更优。
更关键的是,科学家们可以根据不同需求,设计出不同结构的重组胶原蛋白:全长的单链,保留人体天然胶原的所有功能;特定功能片段,可以多次重复串联,强化修护效果;不同功能的片段还能拼接,实现“多功能合一”。
目前,巨子生物已储备了50多种不同型别、序列和功效的重组胶原蛋白,相当于一个“胶原宝库”,可以精准适配不同人群、不同肌肤需求。比如其自主研发的重组Ⅳ型胶原蛋白——一种在皮肤基底膜中起“双面胶”作用的关键成分——已成功应用于明星产品可复美胶原棒2.0中。针对皮肤泛红、敏感等屏障受损问题,这款产品在实测中展现出了显著的修护效果。

二、透皮:攻克“补得进”的行业技术难题
有了“人体同款”的重组胶原蛋白,下一个问题出现了:涂抹在皮肤上,它能吸收多少?这是行业公认的技术难题。
巨子生物用三项核心技术,实现了重组胶原蛋白透皮吸收的重大突破。在实验室里,段博士向主持人详细讲解了这三套方案:
第一,做“小”。把上千个氨基酸的长链截短,或者只选取具有特定功能的肽段进行生产,分子量更小,更易透皮吸收。
第二,折叠“压”小。采用超分子技术,让长链组装、折叠、压缩,物理尺寸大大缩小,轻松穿透皮肤屏障。
第三,脂质体包裹技术。把重组胶原蛋白包在既亲水又亲油的脂质体中,改变分子性质,实现高效透皮。

为了验证透皮效果,段博士展示了通过拉曼实验连续记录12小时的光谱图示,结果显示:这些重组胶原蛋白不仅能穿透表皮,还能稳定停留在真皮层持续发挥作用。实验经过多次重复验证,结果高度一致。

“补得进、留得住、用得上”——这才是科学补胶原的真正含义。
在这3种透皮方法中,超分子技术和脂质体包裹技术已经应用在可复美即将推出的全新次抛精华中。
三、量产:从克级到吨级,中国生物制造啃下“硬骨头”
实验室的成功只是第一步。真正让技术惠及大众的,是量产。
走进巨子生物的生产车间,高大的发酵罐整齐排列,管道纵横,屏幕上实时跳动着温度、压力、溶氧等数据。从克级到吨级,不是简单放大容器,而是指数级增长的工程挑战。菌种驯化、工艺优化、质量控制——成千上万次试验,才换来稳定、安全、高效的量产。


段博士向陈伟鸿坦言:“从克级到吨级,难度是指数级增长的。”为了解决这个难题,巨子生物的科研团队做了大量工作:菌种驯化。不是随便一颗“种子”都能适应大规模发酵。科学家们通过反复筛选和驯化,培育出耐受性强、表达效率高的优势菌株。
“必须走通量产这条路,不然再厉害的生物科技,也很难让大家都用上。”段博士颇为感慨地讲道,正是这种“死磕”精神,让巨子生物成为国内最早啃下重组胶原蛋白量产和商业化这块硬骨头的企业。
如今,一个发酵罐的产能就够100万人用一年,而这样的发酵罐,巨子生物还有很多。并且,巨子生物一直在以医用级的标准来要求每一批次产品,从原料到成品经过多个环节的严格质检,确保做到品质如一。
从克级到吨级,巨子生物不仅打通了技术到产品的“最后一公里”,更让重组胶原蛋白从实验室的遥远“奢侈品”变成了大众目之可及的日常消费用品。

四、初心:让高端生物科技走进每一个普通家庭,守护美丽与健康
2026年,是“十五五”规划开局之年。生物制造,被列为我国将培育壮大的六个未来产业之一。而重组胶原蛋白,正是生物制造产业的典型代表。它用合成生物学技术,把基础研究转化为可量产、可应用的产品,从实验室走向生产线,再走进千家万户。
在探访中,陈伟鸿见到了重组胶原蛋白领域研发的带头人:西北大学范代娣教授。说到研发这一技术成分的初心,”范教授感慨道,“我当时就想,我们中国的科研人,能不能做出一种安全有效、普通人用得起的基础生物材料?”
从医用材料出发,到如今应用于日常护肤,范教授的初心始终没变:用做医用材料的严谨,去做皮肤健康的科学护理。
镜头停留在一面挂满专利证书的墙上,这里展示了满满的授权专利以及各类奖项,包括国家技术发明奖和中国专利金奖,还有巨子生物作为重组胶原蛋白行业标准和团体标准参与和牵头制定单位的证书。

“这一路走来,我们的科研进程中获得过多个国家项目计划的支持,因为重组胶原蛋白的价值,远不止于护肤领域,而是在组织修复、止血、人工器官、再生医学等严肃医疗领域,它都有非常大的应用前景”,范教授表示,“我们希望高端的生物科技,走进更多普通人的生活,让每个人都能享受到科技带来的美好。未来,我们还会继续深耕,创新更多生物活性成分,助力中国生物制造走向世界,用科技力量守护每个人的美丽和健康。”

从一颗研发的初心,到20多年的坚守;从实验室的克级样品,到工厂的吨级量产;从产学研医深度融合,到行业标准、团体标准的制定——巨子生物用技术和坚持,诠释了中国生物科技的力量。
这场探访,不仅揭开了一项生物科技的面纱,更让我们看到:中国,有能力把一项技术做成产品,把一款产品做成产业,把一个产业做成国家拿得出手的名片。
结语
科技最动人的样子,不是高高在上的论文与专利,而是化成精华、变成面霜,走进每一个家庭,呵护每一张脸,守护每一份健康。
从一颗微生物“种子”,到普通人梳妆台上的产品;从填补国内空白,到引领行业标准——重组胶原蛋白的突破,不仅是一场技术革新,更是中国生物制造赋能健康生活的有力证明。
“十五五”已来,生物制造的浪潮正起。我们有理由相信,会有更多中国生物科技企业,用硬核技术,解锁更多生命的奥秘,让科技温暖生活。 |